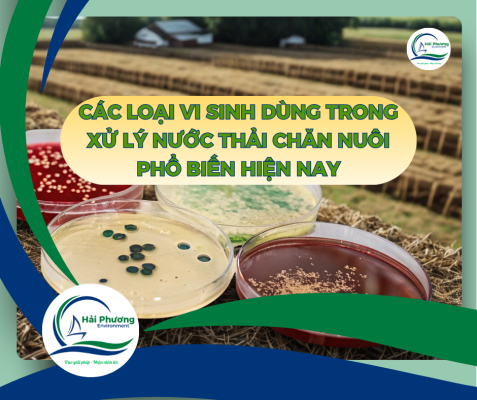
Các Loại Vi Sinh Dùng Trong Xử Lý Nước Thải Chăn Nuôi

QUY TRÌNH XỬ LÝ NƯỚC THẢI NHÀ MÁY DA THUỘC
Quy Trình Xử Lý Nước Thải Nhà MáySản Xuất Và Chế Biến Da Thuộc Đạt [...]
SỰ CỐ BÙN PHÁT SINH NHIỀU, KHÓ LẮNG TRONG HỆ THỐNG XỬ LÝ NƯỚC THẢI CHĂN NUÔI
Xử Lý Sự Cố Bùn Phát Sinh Nhiều, Khó Lắng Trong Hệ Thống Xử Lý [...]
QUY TRÌNH XÂY DỰNG HỆ THỐNG XỬ LÝ NƯỚC THẢI DẠNG BỂ COMPOSITE
Quy Trình Xây Dựng Hệ Thống Xử Lý Nước ThảiDạng Bể Composite Chuẩn Kỹ Thuật [...]
ĐẶC THÙ NƯỚC THẢI NGÀNH DA THUỘC
Đặc Thù Nước Thải Nhà Máy Sản Xuất Và Chế Biến Da Thuộc– Thành Phần, [...]
ĐIỀU LƯU Ý KHI LẮP ĐẶT HỆ THỐNG XỬ LÝ NƯỚC THẢI KHÁCH SẠN
Những Điều Cần Chú Ý Khi Lắp ĐặtHệ Thống Xử Lý Nước Thải Khách Sạn [...]
KHI NÀO CẦN BẢO TRÌ HỆ THỐNG XỬ LÝ NƯỚC THẢI NHÀ HÀNG?
Khi Nào Cần Bảo Trì Hệ Thống Xử Lý Nước Thải Nhà Hàng?Dấu Hiệu & [...]
TÌM HIỂU VỀ BỂ KỴ KHÍ TRONG XỬ LÝ NƯỚC THẢI
Tìm Hiểu Về Bể Kỵ Khí Trong Xử Lý Nước Thải:Nguyên Lý, Ưu Điểm Và [...]
QUY TRÌNH XỬ LÝ NƯỚC THẢI NHÀ MÁY CHẾ BIẾN GỖ ĐẠT CHUẨN
Quy Trình Xử Lý Nước Thải Nhà Máy Chế Biến Gỗ Đạt Chuẩn – Hiệu [...]
CÔNG NGHỆ RO – UF – NANO TRONG XỬ LÝ NƯỚC CẤP
Công Nghệ RO – UF – Nano Trong Xử Lý Nước Cấp:Giải Pháp Tối Ưu [...]
CÁC LOẠI VI SINH DÙNG TRONG XỬ LÝ NƯỚC THẢI CHĂN NUÔI
Các Loại Vi Sinh Dùng Trong Xử Lý Nước Thải Chăn Nuôi Phổ Biến Hiện [...]